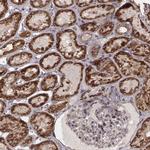
ZDHHC21 Antibody in Immunohistochemistry (Paraffin) (IHC (P))

Search
Invitrogen
ZDHHC21 Polyclonal Antibody
{{$productOrderCtrl.translations['antibody.pdp.commerceCard.promotion.promotions']}}
{{$productOrderCtrl.translations['antibody.pdp.commerceCard.promotion.viewpromo']}}
{{$productOrderCtrl.translations['antibody.pdp.commerceCard.promotion.promocode']}}: {{promo.promoCode}} {{promo.promoTitle}} {{promo.promoDescription}}. {{$productOrderCtrl.translations['antibody.pdp.commerceCard.promotion.learnmore']}}
产品信息
PA5-66757
种属反应
宿主/亚型
分类
类型
偶联物
形式
浓度
规格
纯化类型
保存液
内含物
保存条件
运输条件
RRID
产品详细信息
Immunogen sequence: RASITDPGRLP ENPKIPHGER EFWELCNKCN LMRPKRSHHC SRCGHCVRRM
Highest antigen sequence identity to the following orthologs - mouse 94%, rat 94%.
靶标信息
Palmitoylates sex steroid hormone receptors, including ESR1, PGR and AR, thereby regulating their targeting to the plasma membrane. This affects rapid intracellular signaling by sex hormones via ERK and AKT kinases and the generation of cAMP, but does not affect that mediated by their nuclear receptor. [UniProt]
仅用于科研。不用于诊断过程。未经明确授权不得转售。
篇参考文献 (0)
生物信息学
蛋白别名: DHHC domain-containing cysteine-rich protein 21; DHHC-21; Palmitoyltransferase ZDHHC21; unnamed protein product; Zinc finger DHHC domain-containing protein 21; zinc finger DHHC-type containing 21; zinc finger DHHC-type palmitoyltransferase 21; zinc finger, DHHC domain containing 21
基因别名: DHHC-21; DHHC21; DNZ1; HSPC097; ZDHHC21
UniProt ID: (Human) Q8IVQ6
Entrez Gene ID: (Human) 340481